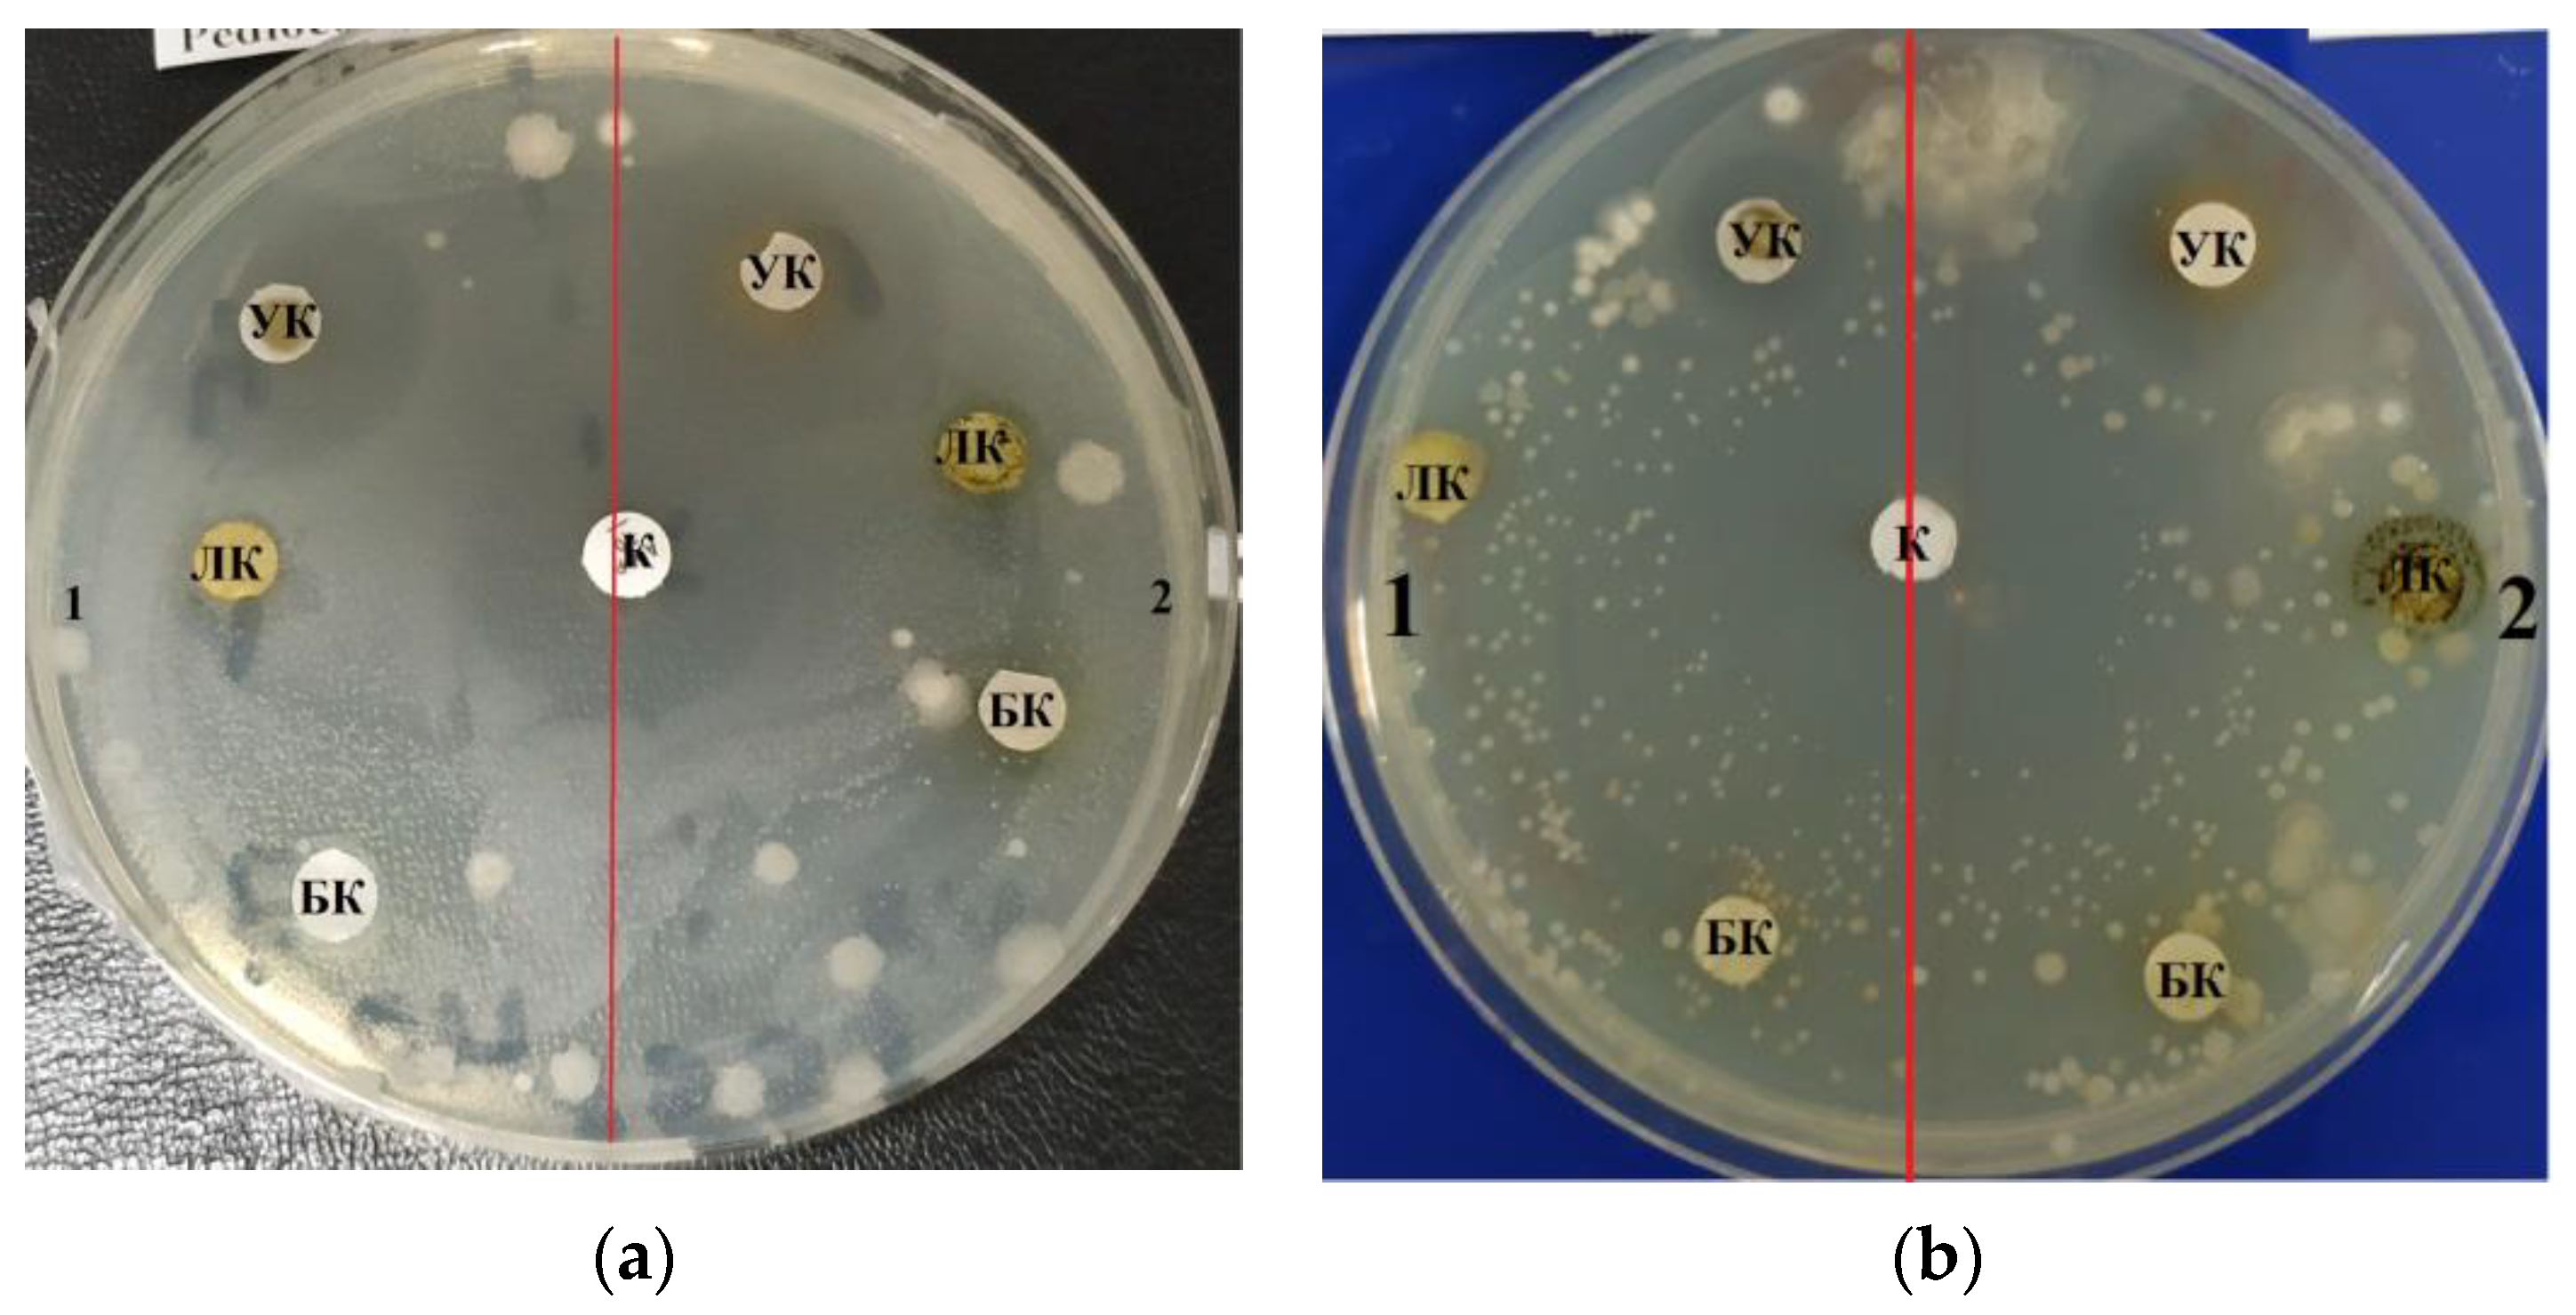
Life 12 01395 g001 550
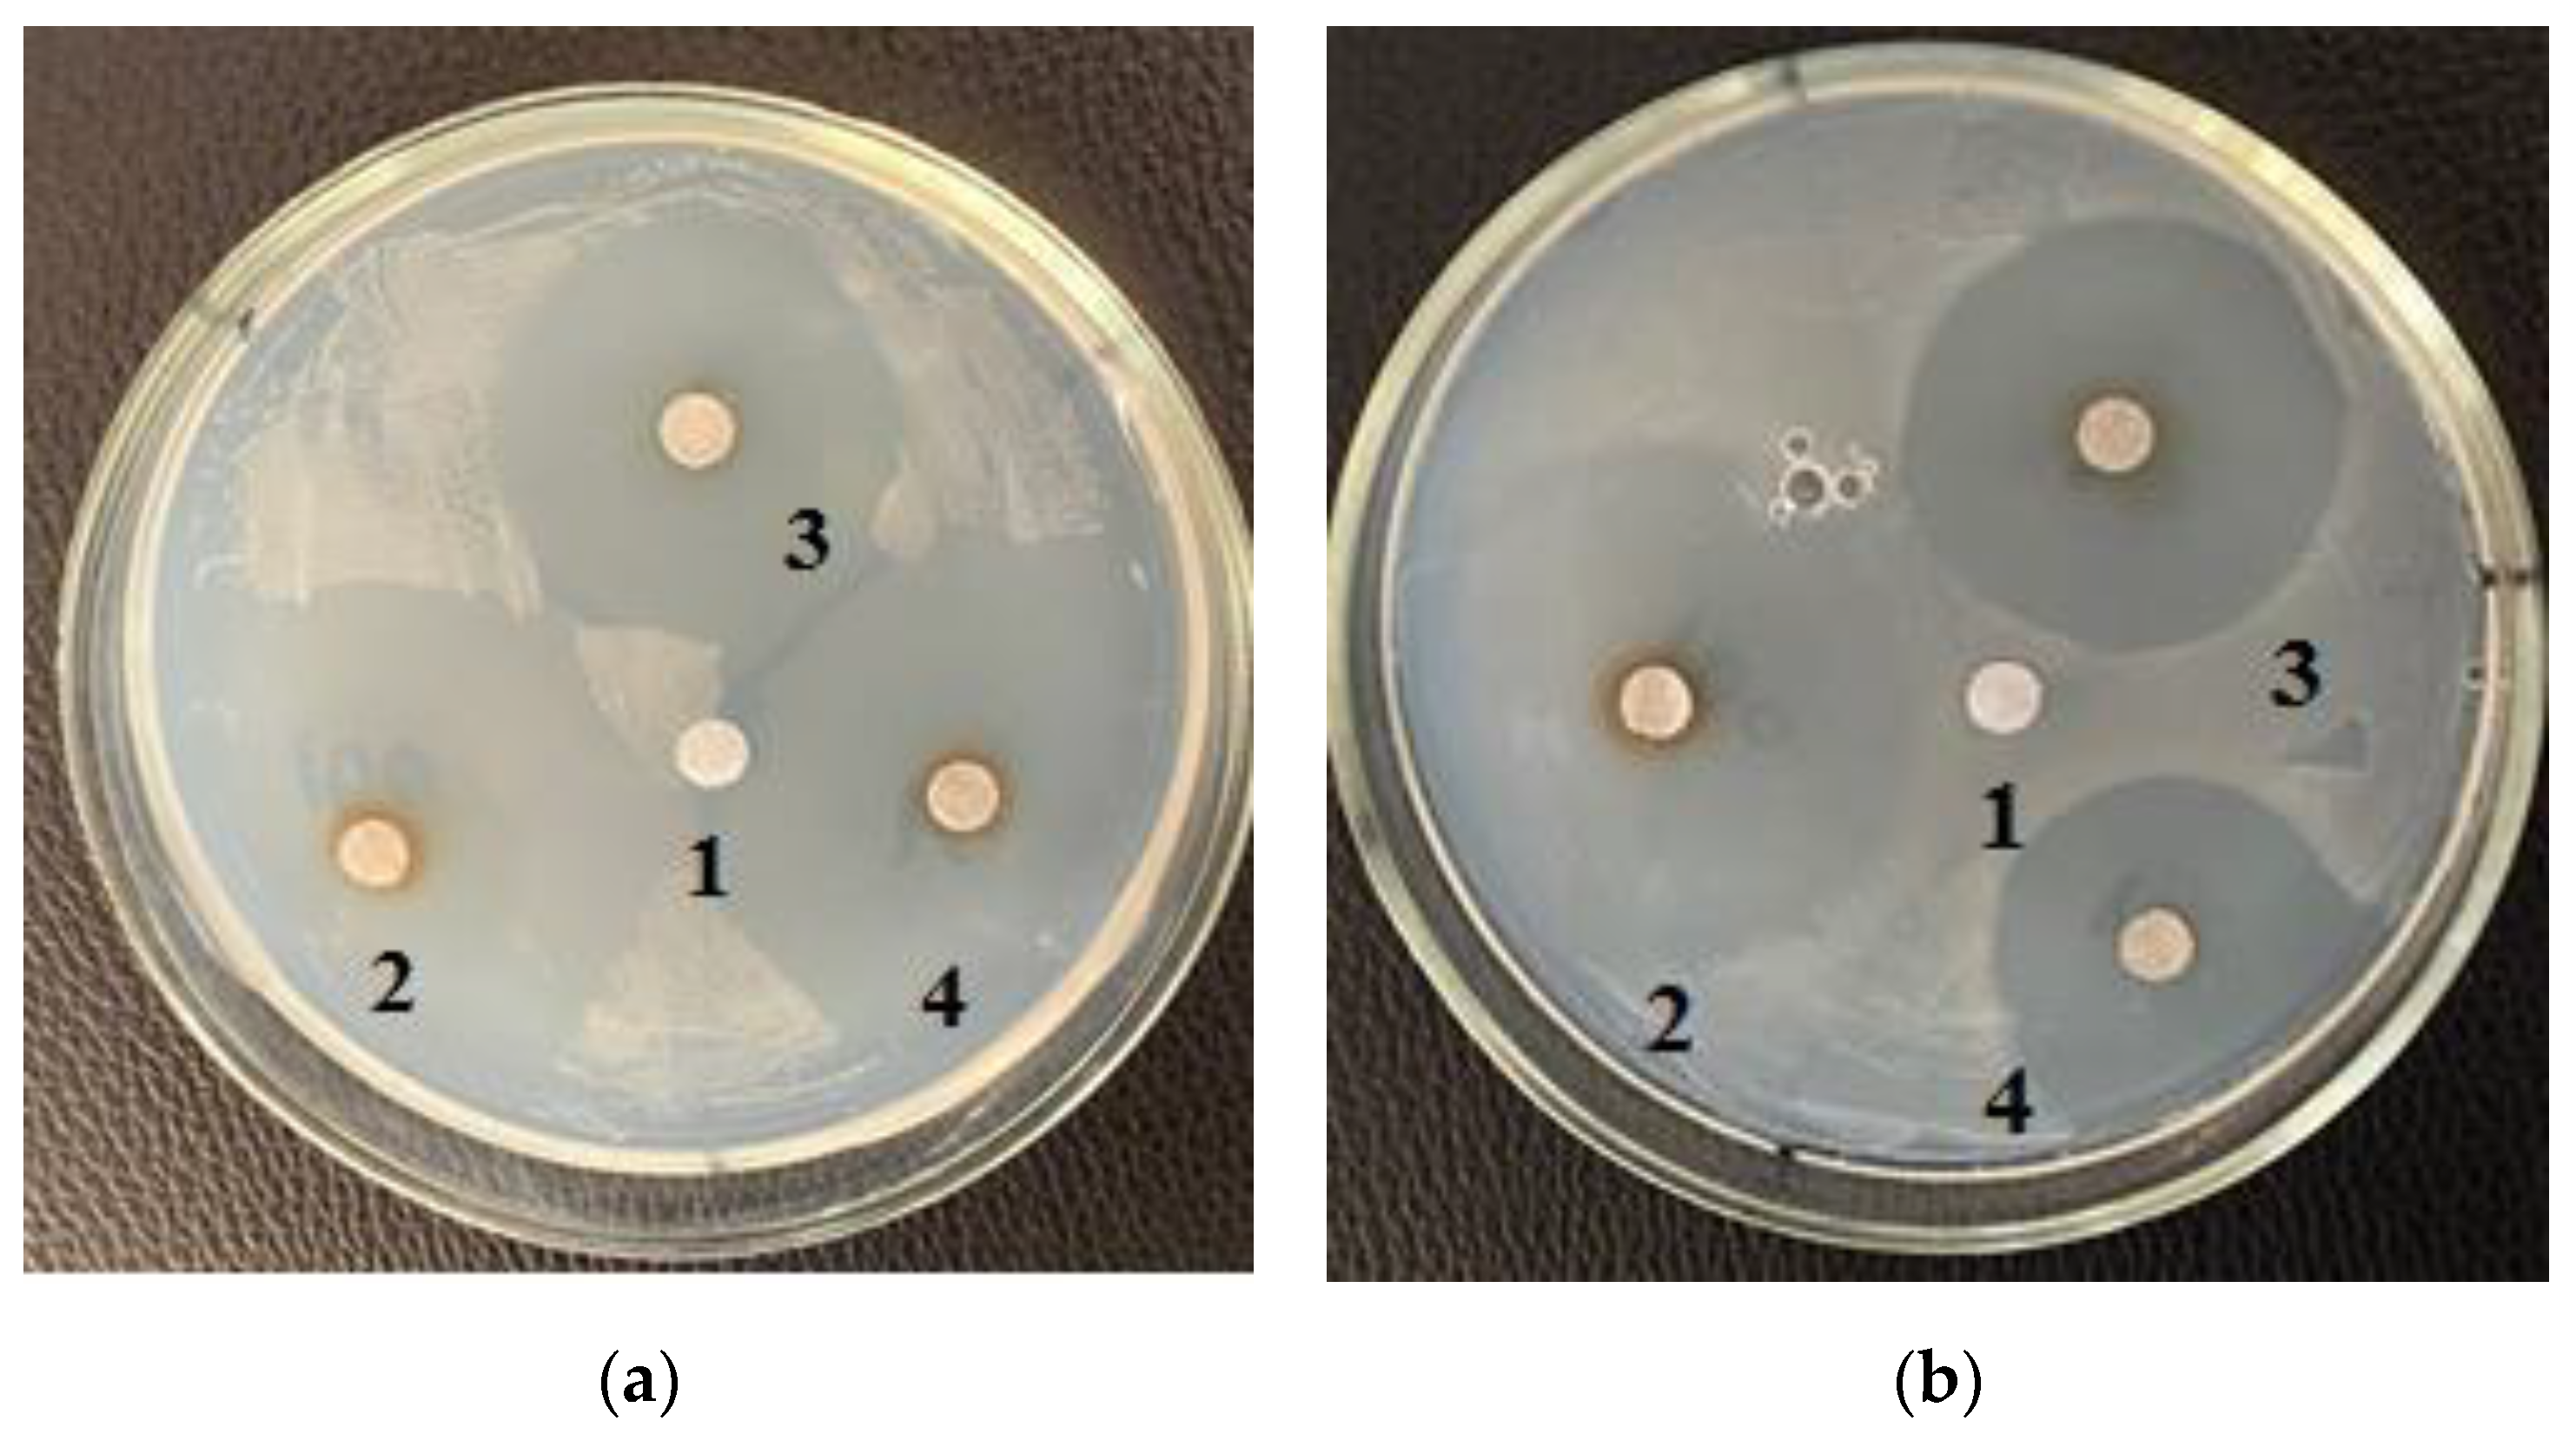
Life 12 01395 g003 550

Identification of Metabolites with Antibacterial Activities by Analyzing the FTIR Spectra of Microalgae
Abstract
:1. Introduction
2. Materials and Methods
2.1. Materials
2.2. Microalgae Samples
2.3. Extraction of Protein Concentrate, Lipid and Carbohydrate Complexes
2.4. Determination of the Antibiotic Activity of Microalgae
2.5. FTIR Spectroscopy
2.6. Statistical Analysis
3. Results
4. Discussion
5. Conclusions
Author Contributions
Funding
Institutional Review Board Statement
Informed Consent Statement
Data Availability Statement
Conflicts of Interest
References
- MacDonnell, C.; Tiling, K.; Encomio, V.; van der Heide, T.; Teunis, M.; Lengkeek, W.; Didderen, K.; Bouma, T.J.; Inglett, P.W. Evaluating a novel biodegradable lattice structure for subtropical seagrass restoration. Aquat. Bot. 2022, 176, 103463. [Google Scholar] [CrossRef]
- Mousavian, Z.; Safavi, M.; Azizmohseni, F.; Hadizadeh, M.; Mirdamadi, S. Characterization, antioxidant and anticoagulant properties of exopolysaccharide from marine microalgae. AMB Expr. 2022, 12, 27. [Google Scholar] [CrossRef] [PubMed]
- Song, I.; Kim, S.; Kim, J.; Oh, H.; Jang, J.; Jeong, S.J.; Baek, K.; Shin, W.-S.; Sim, S.J.; Jin, E. Macular pigment-enriched oil production from genome-edited microalgae. Microb. Cell Fact. 2022, 21, 27. [Google Scholar] [CrossRef]
- Dolganyuk, V.; Belova, D.; Babich, O.; Prosekov, A.; Ivanova, S.; Katserov, D.; Patyukov, N.; Sukhikh, S. Microalgae: A Promising Source of Valuable Bioproducts. Biomolecules 2020, 10, 1153. [Google Scholar] [CrossRef] [PubMed]
- Morin-Crini, N.; Lichtfouse, E.; Torri, G.; Crini, G. Applications of chitosan in food, pharmaceuticals, medicine, cosmetics, agriculture, textiles, pulp and paper, biotechnology, and environmental chemistry. Environ. Chem. Lett. 2019, 17, 1667–1692. [Google Scholar] [CrossRef]
- Villarruel-Lopez, A.; Ascencio, F.; Nuno, K. Microalgae, a potential natural functional food source—A review. Pol. J. Food Nutr. Sci. 2017, 67, 251–263. [Google Scholar] [CrossRef]
- Kadkhodeaei, S.; Abbasiliasi, S.; Shun, T.J.; Masoumi, H.R.F.; Mohamed, M.S.; Movahedi, A.; Rahim, R.; Ariff, A.B. Enhancement of protein production by microalgae Dunaliella salina under mixotrophic condition using response surface methodology. RSC Adv. 2015, 5, 38141–38151. [Google Scholar] [CrossRef]
- Goiris, K.; Van-Colen, W.; Wilches, I.; León-Tamariz, F.; De Cooman, L.; Muylaert, K. Impact of nutrient stress on antioxidant production in three species of microalgae. Algal Res. 2015, 7, 51–57. [Google Scholar] [CrossRef]
- Loganathan, G.; Valerie, B.O.; Mark, L. Valuable bioproducts obtained from microalgal biomass and their commercial applications: A review. Environ. Eng. Res. 2018, 23, 229–241. [Google Scholar] [CrossRef]
- Rincon, S.M.; Urrego, N.F.; Avila, K.J.; Romero, H.M.; Beyenal, H. Photosynthetic activity assessment in mixotrophically cultured Chlorella vulgaris biofilms at various developmental stages. Algal Res. 2019, 38, 101408. [Google Scholar] [CrossRef]
- Chia, S.R.; Chew, K.W.; Zaid, H.F.M.; Chu, D.T.; Tao, Y.; Show, P.L. Microalgal protein extraction from Chlorella vulgaris FSP-E using triphasic partitioning technique with sonication. Front. Bioeng. Biotechnol. 2019, 7, 396. [Google Scholar] [CrossRef] [PubMed]
- Anthony, J.; Sivashankarasubbiah, K.T.; Thonthula, S.; Rangamaran, V.R.; Gopal, D.; Ramalingam, K. An efficient method for the sequential production of lipid and carotenoids from the Chlorella Growth Factor-extracted biomass of Chlorella vulgaris. J. Appl. Phycol. 2018, 30, 2325–2335. [Google Scholar] [CrossRef]
- Widowati, I.; Zainuri, M.; Kusumaningrum, H.P.; Susilowati, R.; Hardivillier, Y.; Leignel, V.; Bourgougnon, N.; Mouget, J.-L. Antioxidant activity of three microalgae Dunaliella salina, Tetraselmis chuii and Isochrysis galbana clone Tahiti. IOP Conference Series: Earth and Environmental Science 2017, Volume 55, 012067. [Google Scholar] [CrossRef]
- Pradhan, B.; Nayak, R.; Patra, S.; Jit, B.P.; Ragusa, A.; Jena, M. Bioactive Metabolites from Marine Algae as Potent Pharmacophores against Oxidative Stress-Associated Human Diseases: A Comprehensive Review. Molecules 2021, 26, 37. [Google Scholar] [CrossRef]
- Pradhan, B.; Patra, S.; Nayak, R.; Behera, C.; Dash, S.R.; Nayak, S.; Sahu, B.B.; Bhutia, S.K.; Jena, M. Multifunctional role of fucoidan, sulfated polysaccharides in human health and disease: A journey under the sea in pursuit of potent therapeutic agents. Int. J. Biol. Macromol. 2020, 164, 4263–4278. [Google Scholar] [CrossRef] [PubMed]
- Patra, S.; Praharaj, P.P.; Panigrahi, D.P.; Panda, B.; Bhol, C.S.; Mahapatra, K.K.; Mishra, S.R.; Behera, B.P.; Jena, M.; Sethi, G.; et al. Bioactive compounds from marine invertebrates as potent anticancer drugs: The possible pharmacophores modulating cell death pathways. Mol. Biol. Rep. 2020, 47, 7209–7228. [Google Scholar] [CrossRef] [PubMed]
- Bouzidi, N.; Viano, Y.; Ortalo-Magne, A.; Seridi, H.; Alliche, Z.; Daghbouche, Y.; Culioli, G.; El Hattab, M. Sterols from the brown alga Cystoseira foeniculacea: Degradation of fucosterol into saringosterol epimers. Arab. J. Chem. 2019, 12, 1474–1478. [Google Scholar] [CrossRef]
- Tanna, B.; Mishra, A. Metabolites unravel nutraceutical potential of edible seaweeds: An emerging source of functional food. Compr. Rev. Food Sci. Food Saf. 2018, 17, 1613–1624. [Google Scholar] [CrossRef]
- Alsenani, F.; Tupally, K.R.; Chua, E.T.; Eltanahy, E.; Alsufyani, H.; Parekh, H.S.; Schenk, P.M. Evaluation of microalgae and cyanobacteria as potential sources of antimicrobial compounds. Saudi Pharm J. 2020, 28, 1834–1841. [Google Scholar] [CrossRef]
- Bhattacharjee, M. Pharmaceutically valuable bioactive compounds of algae. Asian J. Pharm. Clin. Res. 2016, 7, 43–47. [Google Scholar] [CrossRef]
- Niveshika; Verma, E.; Mishra, A.K.; Singh, A.K.; Singh, V.K. Structural Elucidation and Molecular Docking of a Novel Antibiotic Compound from Cyanobacterium Nostoc sp. MGL001. Front. Microbiol. 2016, 29, 1899. [Google Scholar] [CrossRef]
- Otero, P.; Quintana, S.E.; Reglero, G.; Fornari, T.; García-Risco, M.R. Pressurized Liquid Extraction (PLE) as an Innovative Green Technology for the Effective Enrichment of Galician Algae Extracts with High Quality Fatty Acids and Antimicrobial and Antioxidant Properties. Mar. Drugs 2018, 16, 156. [Google Scholar] [CrossRef] [PubMed]
- Dolganyuk, V.; Andreeva, A.; Budenkova, E.; Sukhikh, S.; Babich, O.; Ivanova, S.; Prosekov, A.; Ulrikh, E. Study of Morphological Features and Determination of the Fatty Acid Composition of the Microalgae Lipid Complex. Biomolecules 2020, 10, 1571. [Google Scholar] [CrossRef] [PubMed]
- Andreeva, A.; Budenkova, E.; Babich, O.; Sukhikh, S.; Ulrikh, E.; Ivanova, S.; Prosekov, A.; Dolganyuk, V. Production, Purification, and Study of the Amino Acid Composition of Microalgae Proteins. Molecules 2021, 26, 2767. [Google Scholar] [CrossRef]
- Tchuenkam, T.; Flore, T.; Tiencheu, B.; Tenyang, N.; Oben, A.; Ashu, E.; Marie, M.; Achidi, A.; Marie, E. Chemical and antibacterial properties of lipids extracted from some plant seeds and fruits commonly used in cosmetics. Am. J. Food Sci. Technol. 2022, 10, 10–19. [Google Scholar] [CrossRef]
- Lampropoulos, P.K.; Gkentzi, D.; Tzifas, S.; Dimitriou, G. Neonatal Sepsis Due to Bacillus subtilis. Cureus 2021, 13, e17692. [Google Scholar] [CrossRef]
- Dent, G. Preparation of Samples for IR Spectroscopy as KBr Disks. Int. J. Vib. Spect. 1996, 1, 2. [Google Scholar]
- Kottuparambil, S.; Thankamony, R.L.; Agusti, S. Euglena as a potential natural source of value-added metabolites. A review. Algal Res. 2019, 37, 154–159. [Google Scholar] [CrossRef]
- Ru, I.T.K.; Sung, Y.Y.; Jusoh, M.; Wahid, M.E.A.; Nagappan, T. Chlorella vulgaris: A perspective on its potential for combining high biomass with high value bioproducts. Appl. Phycol. 2020, 1, 2–11. [Google Scholar] [CrossRef]
- Garcia, L.C. The promises of Chlorella vulgaris as the best alternative for biodiesel: A review. J. Nat. Stud. 2012, 11, 103–123. [Google Scholar]
- Yeh, K.L.; Chang, J.S. Effects of cultivation conditions and media composition on cell growth and lipid productivity of indigenous microalga Chlorella vulgaris ESP-31. Bioresour. Technol. 2012, 105, 120–127. [Google Scholar] [CrossRef]
- Choix, F.J.; de-Bashan, L.E.; Bashan, Y. Enhanced accumulation of starch and total carbohydrates in alginateimmobilized Chlorella spp. induced by Azospirillum brasilense: I. Autotrophic conditions. Enzym. Microb. Technol. 2012, 51, 294–299. [Google Scholar] [CrossRef] [PubMed]
- Abdelhedi, O.; Jridi, M.; Msaddak, L.; Belaid, A.; Nasri, M.; Zouari, N.; Fakhfakh, N. Spirulina (Arthrospira) Platensis as a Techno-Functional Ingredient in Almond Paste Process Production. Austin. J. Nutri. Food Sci. 2019, 7, 1116. [Google Scholar]
- Zielinski, D.; Fraczyk, J.; Debowski, M.; Zielinski, M.; Kaminski, Z.; Kregiel, D.; Jacob, C.; Kolesinska, B. Biological Activity of Hydrophilic Extract of Chlorella vulgaris Grown on Post-Fermentation Leachate from a Biogas Plant Supplied with Stillage and Maize Silage. Molecules 2020, 25, 1790. [Google Scholar] [CrossRef]
- Frazzini, S.; Scaglia, E.; Dell’Anno, M.; Reggi, S.; Panseri, S.; Giromini, C.; Lanzoni, D.; Sgoifo Rossi, C.A.; Rossi, L. Antioxidant and Antimicrobial Activity of Algal and Cyanobacterial Extracts: An In Vitro Study. Antioxidants 2022, 11, 992. [Google Scholar] [CrossRef] [PubMed]
- Selivanova, E.A.; Ignatenko, M.E.; Nemtseva, N.V. Antagonistic activity of novel green microalgae strain. Zh. Mikrobiol. Epidemiol. Immunobiol. 2014, 4, 72–76. [Google Scholar]
- Pina-Pérez, M.C.; Rivas, A.; Martínez, A.; Rodrigo, D. Antimicrobial potential of macro and microalgae against pathogenic and spoilage microorganisms in food. Food Chem. 2017, 235, 34–44. [Google Scholar] [CrossRef]
- Singh, M.; Singh, S.; Prasad, S.; Gambhir, I. Nanotechnology in medicine and antibacterial effect of silver nanoparticles. Digest J. Nanomater. Biostructures 2008, 3, 115–122. [Google Scholar]
- Mostafa, S.M.S. Microalgal biotechnology: Prospects and applications. In Plant Science; Kumar, D.N., Ed.; IntechOpen Ltd.: London, UK, 2012; pp. 275–314. [Google Scholar]
- Ahmad, M.T.; Shariff, M.; Yusoff, F.M.; Goh, Y.M.; Banerjee, S. Applications of microalga Chlorella vulgaris in aquaculture. Rev. Aquac. 2018, 1, 328–346. [Google Scholar]
- Safi, C.; Zebib, B.; Merah, O.; Pontalier, P. Morphology, composition, production, processing and applications of Chlorella vulgaris: A review. Renew. Sustain. Energy Rev. 2014, 35, 265–278. [Google Scholar] [CrossRef]
- Tabarsa, M.; Shin, I.S.; Lee, J.H.; Surayot, U.; Park, W.; You, S. An immune-enhancing water-soluble α glucan from Chlorella vulgaris and structural characteristics. Food Sci. Biotechnol. 2015, 24, 1933–1941. [Google Scholar] [CrossRef]
- Scott, A.M.; Beller, E.; Glasziou, P.; Clark, J.; Ranakusuma, R.W.; Byambasuren, O.; Bakhit, M.; Page, S.W.; Trott, D.; Del Mar, C. Is Antimicrobial Administration to Food Animals a Direct Threat to Human Health? A Rapid Systematic Review. Int. J. Antimicrob. Agents 2018, 52, 316–323. [Google Scholar] [CrossRef] [PubMed]
- Sharma, C.; Rokana, N.; Chandra, M.; Singh, B.P.; Gulhane, R.D.; Gill, J.P.S.; Ray, P.; Puniya, A.K.; Panwar, H. Antimicrobial Resistance: Its Surveillance, Impact, and Alternative Management Strategies in Dairy Animals. Front. Vet. Sci. 2018, 4, 237. [Google Scholar] [CrossRef] [PubMed]
- Caprarulo, V.; Hejna, M.; Giromini, C.; Liu, Y.; Dell’Anno, M.; Sotira, S.; Reggi, S.; Sgoifo-Rossi, C.A.; Callegari, M.L.; Rossi, L. Evaluation of Dietary Administration of Chestnut and Quebracho Tannins on Growth, Serum Metabolites and Fecal Parameters of Weaned Piglets. Animals 2020, 10, 1945. [Google Scholar] [CrossRef] [PubMed]
- Ricky, R.; Chiampo, F.; Shanthakumar, S. Efficacy of Ciprofloxacin and Amoxicillin Removal and the Effect on the Biochemical Composition of Chlorella vulgaris. Bioengineering 2022, 9, 134. [Google Scholar] [CrossRef]
- Bhuvaneswari, G.R.; Shukla, S.P.; Makesh, M.; Thirumalaiselvan, S.; Sudhagar, S.A.; Kothari, D.C.; Singh, A. Antibacterial Activity of Spirulina (Arthospira platensisGeitler) against Bacterial Pathogens in Aquaculture. Isr. J. Aquac.-Bamidgeh 2013, 932, 1–8. [Google Scholar]
- Daglia, M. Polyphenols as antimicrobial agents. Curr. Opin. Biotechnol. 2012, 23, 174–181. [Google Scholar] [CrossRef]
- Etahiri, S.; Bultel-Poncé, V.; Caux, C.; Guyot, M. New Bromoditerpenes from the Red Alga Sphaerococcus Coronopifolius. J. Nat. Prod. 2001, 64, 1024–1027. [Google Scholar] [CrossRef] [PubMed]
- Darias, J.; Rovirosa, J.; San Martin, A.; Díaz, A.-R.; Dorta, E.; Cueto, M. Furoplocamioids A−C, Novel Polyhalogenated Furanoid Monoterpenes from Plocamium c Artilagineum. J. Nat. Prod. 2001, 64, 1383–1387. [Google Scholar] [CrossRef]
- Barreto, M.; Meyer, J.J.M. Isolation and Antimicrobial Activity of a Lanosol Derivative from Osmundaria Serrata (Rhodo-phyta) and a Visual Exploration of Its Biofilm Covering. S. Afr. J. Bot. 2006, 72, 521–528. [Google Scholar] [CrossRef]
- Kavita, K.; Singh, V.K.; Jha, B. 24-Branched ∆5 Sterols from Laurencia Papillosa Red Seaweed with Antibacterial Activity against Human Pathogenic Bacteria. Microbiol. Res. 2014, 169, 301–306. [Google Scholar] [CrossRef]
- das Neves dos Santos Amorim, R.; Rodrigues, J.A.G.; Holanda, M.L.; Quinderé, A.L.G.; de Paula, R.C.M.; Melo, V.M.M.; Benevides, N.M.B. Antimicrobial Effect of a Crude Sulfated Polysaccharide from the Red Seaweed Gracilaria Ornata. Braz. Arch. Biol. Technol. 2012, 55, 171–181. [Google Scholar] [CrossRef]
- Stabili, L.; Acquaviva, M.I.; Biandolino, F.; Cavallo, R.A.; de Pascali, S.A.; Fanizzi, F.P.; Narracci, M.; Petrocelli, A.; Cecere, E. The Lipidic Extract of the Seaweed Gracilariopsis Longissima (Rhodophyta, Gracilariales): A Potential Resource for Bio-technological Purposes? New Biotechnol. 2012, 29, 443–450. [Google Scholar] [CrossRef]
- Abdel-Moneim, A.-M.E.; El-Saadony, M.T.; Shehata, A.M.; Saad, A.M.; Aldhumri, S.A.; Ouda, S.M.; Mesalam, N.M. Antioxi-dant and Antimicrobial Activities of Spirulina Platensis Extracts and Biogenic Selenium Nanoparticles against Selected Pathogenic Bacteria and Fungi. Saudi J. Biol. Sci. 2022, 29, 1197–1209. [Google Scholar] [CrossRef] [PubMed]
- Zhao, T.; Han, X.; Cao, H. Effect of Temperature on Biological Macromolecules of Three Microalgae and Application of FT-IR for Evaluating Microalgal Lipid Characterization. ACS Omega 2020, 5, 33262–33268. [Google Scholar] [CrossRef] [PubMed]
- Nosenko, T.; Sitnikova, V.; Strelnikova, I.; Fokina, M. Workshop on Vibrational Spectroscopy; ITMO University: St. Petersburg, Russia, 2021; pp. 125–135. [Google Scholar]
- Alghazeer, R.; Whida, F.; Abduelrhman, E.; Gammoudi, F.; Azwai, S. Screening of antibacterial activity in marine green, red and brown macroalgae from the western coast of Libya. Nat. Sci. 2013, 5, 7–14. [Google Scholar] [CrossRef]
- Sun, H.; Song, W.; Zhang, L.; Yang, X.; Zhu, Z.; Ma, R.; Wang, D. Structural characterization and inhibition on Į-glucosidase of a novel oligosaccha-ride from barley malt. J. Cereal. Sci. 2018, 28, 82–93. [Google Scholar] [CrossRef]
- Wang, C.; Zhang, D.; Zhang, M.; Jiao, Y.; Jiang, K.; Yan, C. Structural characterization of a novel oligosaccharide from Achyranthes bi-dentata and its anti-osteoporosis activities. Ind. Crop Prod 2017, 108, 458–469. [Google Scholar] [CrossRef]
- Meng, Y.; Yao, C.; Xue, S.; Yang, H. Application of Fourier transform infrared (FT-IR) spectroscopy in determination of mi-croalgal compositions. Bioresour. Technol. 2014, 151, 347–354. [Google Scholar] [CrossRef]
- Dalal, S.R.; Hussein, M.H.; El-Naggar, N.E.-A.; Mostafa, S.I.; Shaaban-Dessuuki, S.A. Characterization of alginate extracted from Sargassum latifolium and its use in Chlorella vulgaris growth promotion and riboflavin drug delivery. Sci. Rep. 2021, 11, 16741. [Google Scholar] [CrossRef]
- Flórez-Fernández, N.; Domínguez, H.; Torres, M.D. A green approach for alginate extraction from Sargassum muticum brown seaweed using ultrasound-assisted technique. Int. J. Biol. Macromol. 2019, 124, 451–459. [Google Scholar] [CrossRef]
- Aprilliza, M. Characterization and properties of sodium alginate from brown algae used as an ecofriendly superabsorbent. In IOP Conference Series: Materials Science and Engineering; IOP Publishing: Bristol, UK, 2017; Volume 188, p. 12019. [Google Scholar] [CrossRef]
- Vidyadharani, G.; Dhandapani, R. Fourier transform infrared (FTIR) spectroscopy for the analysis of lipid from Chlorella vulgaris. Elixir Appl. Biol. 2013, 61, 16753–16756. [Google Scholar]
- Stojanovic, R.; Belscak-Cvitanovic, A.; Manojlovic, V.; Komes, D.; Nedovic, V.; Bugarski, B. Encapsulation of thyme (Thymus serpyllum L.) aqueous extract in calcium alginate beads. J. Sci. Food Agric. 2012, 92, 685–696. [Google Scholar] [CrossRef] [PubMed]
- Carpenter, J.; Saharan, V.K. Ultrasonic assisted formation and stability of mustard oil in water nanoemulsion: Effect of pro-cess parameters and their optimization. Ultrason. Sonochem. 2017, 35, 422–430. [Google Scholar] [CrossRef]
- Cardenas-Jiron, G.; Leal, D.; Matsuhiro, B.; Osorio-Roman, I.O. Vibrational spectroscopy and density functional theory cal-culations of poly-D-mannuronate and heteropolymeric fractions from sodium alginate. J. Raman Spectrosc. 2011, 42, 870–878. [Google Scholar] [CrossRef]
- Bouissil, S.; El Alaoui-Talibi, Z.; Pierre, G.; Michaud, P.; El Modafar, C.; Delattre, C. Use of alginate extracted from Moroccan brown algae to stimulate natural defense in date palm roots. Molecules 2020, 25, 720. [Google Scholar] [CrossRef] [PubMed]
- Gomaa, M.; Fawzy, M.A.; Hifney, A.F.; Abdel-Gawad, K.M. Use of the brown seaweed Sargassum latifolium in the design of alginate-fucoidan based films with natural antioxidant properties and kinetic modeling of moisture sorption and polyphenolic release. Food Hydrocoll. 2018, 82, 64–72. [Google Scholar] [CrossRef]
- El-Naggar, N.E.-A.; Hussein, M.H.; Shaaban-Dessuuki, S.A.; Dalal, S.R. Production, ex-traction and characterization of Chlorella vulgaris soluble polysaccharides and their ap-plications in AgNPs biosynthesis and biostimulation of plant growth. Sci. Rep. 2020, 10, 3011. [Google Scholar] [CrossRef]
- Activityradhika, D.; Mohaideen, A. Transform infrared analysis of ulva lactuca and gracilaria corticata and their effect on antibacterial. Asian J. Pharm. Clin. Res. 2015, 8, 209–212. [Google Scholar]
- AftabUddin, S.; Siddique, M.A.M.; Habib, A.; Akter, S.; Hossen, S.; Tan-changya, P.; Al, M.A. Effects of seaweeds extract on growth, survival, antibacterial activities, and immune re-sponses of Penaeus monodon against Vibrio parahaemolyticus. Ital. J. Anim. Sci. 2021, 20, 243–255. [Google Scholar] [CrossRef]
- Samper-Villarreal, J.; Moya-Ramírez, J.; Cortés, J. First characterization of seagrasses at Sámara Bay, Pacific coast of Costa Rica. Aquat. Bot. 2022, 178, 103486. [Google Scholar] [CrossRef]
- Thibaut, T.; Blanfuné, A.; Boudouresque, C.F.; Holon, F.; Agel, N.; Descamps, P.; Deter, J.; Pavy, T.; Delaruelle, G.; Verlaque, M. Distribution of the seagrass Halophila stipulacea: A big jump to the northwestern Mediterranean Sea. Aquat. Bot. 2022, 176, 103465. [Google Scholar] [CrossRef]

| Strain | Control (Ampicillin) | Lipid Complex | ||
|---|---|---|---|---|
| 100.0 mg/mL | 10.0 mg/mL | 1.0 mg/mL | ||
| E. coli | 3.0 ± 0.09 | 1.0 ± 0.03 | 1.3 ± 0.04 | 1.3 ± 0.04 |
| B. pumilus | 3.0 ± 0.09 | 2.2 ± 0.06 | 1.9 ± 0.05 | 1.9 ± 0.05 |
| B. subtilis | 3.0 ± 0.09 | 1.6 ± 0.04 | 1.5 ± 0.04 | 1.0 ± 0.03 |
| Mean | 3.0 ± 0.09 | 1.6 ± 0.04 | 1.5 ± 0.04 | 1.4 ± 0.03 |
| Strain | Control (Ampicillin) | Lipid Complex | ||
|---|---|---|---|---|
| 100.0 mg/mL | 10.0 mg/mL | 1.0 mg/mL | ||
| E. coli | 3.0 ± 0.09 | 1.0 ± 0.03 | 1.0 ± 0.03 | 1.0 ± 0.03 |
| B. pumilus | 3.0 ± 0.09 | 0.7 ± 0.02 | 0.7 ± 0.02 | 0.7 ± 0.01 |
| B. subtilis | 3.0 ± 0.09 | 0.3 ± 0.01 | 0.3 ± 0.01 | 0.3 ± 0.01 |
| Mean | 3.0 ± 0.09 | 0.6 ± 0.01 | 0.6 ± 0.01 | 0.6 ± 0.01 |
| Strain | Control (Ampicillin) | Carbohydrate Complex | ||
|---|---|---|---|---|
| 100.0 mg/mL | 10.0 mg/mL | 1.0 mg/mL | ||
| E. coli | 3.0 ± 0.09 | 3.0 ± 0.09 | 3.3 ± 0.09 | 3.3 ± 0.09 |
| B. pumilus | 3.0 ± 0.09 | 3.5 ± 0.10 | 3.2 ± 0.09 | 3.2 ± 0.09 |
| B. subtilis | 3.0 ± 0.09 | 2.2 ± 0.16 * | 2.2 ± 0.06 * | 3.5 ± 0.10 |
| Mean | 3.0 ± 0.09 | 2.9 ± 0.11 | 2.9 ± 0.08 | 3.3 ± 0.10 |
| Strain | Control (Ampicillin) | Carbohydrate Complex | ||
|---|---|---|---|---|
| 100.0 mg/mL | 10.0 mg/mL | 1.0 mg/mL | ||
| E. coli | 3.0 ± 0.09 | 3.0 ± 0.09 | 2.4 ± 0.07 | 2.0 ± 0.06 * |
| B. pumilus | 3.0 ± 0.09 | 3.7 ± 0.11 | 2.4 ± 0.10 | 2.0 ± 0.06 * |
| B. subtilis | 3.0 ± 0.09 | 4.2 ± 0.12 * | 3.6 ± 0.10 | 2.5 ± 0.07 |
| Mean | 3.0 ± 0.09 | 3.6 ± 0.09 | 2.8 ± 0.08 | 2.1± 0.06 * |
| No. | C. vulgaris | A. platensis | Theoretical Interpretation |
|---|---|---|---|
| Wavenumber, cm−1 | |||
| 1 | 665 | - | Deformation vibration of the hydroxyl group |
| 2 | 760 | 760 | Out of plane vibrations of C–H bonds of unsaturated fragments and pendulum vibrations of CH2 |
| 3 | 870 | - | Vibrations of molecules in the C=CH2 group |
| 4 | 965 | - | Stretching vibration of C–C bonds between carbons of CH2 groups and carbons related to unsaturated bonds |
| 5 | 1065 | 1070 | Stretching vibrations of C–C bonds of chains; C–O–P stretching vibrations |
| 6 | 1095 | 1090 | Deformation vibrations (angular) of glycerol crosslink |
| 7 | 1185 | 1183 | Stretching vibrations of C–O glycerol crosslink |
| 8 | 1225 | 1224 | Wagging vibrations of CH2 groups |
| 9 | 1283 | 1258 | Deformation vibrations –C–O– bonds |
| 10 | 1350 | - | Deformation vibrations of CH3 groups |
| 11 | - | 1450 | Scissoring vibrations of CH2 groups |
| 12 | 1448 | - | Deformation vibrations of C–H |
| 13 | 1474 | 1450 | Scissoring vibrations of CH2 groups |
| 14 | 1523 | 1515 | Conjugation of two or more –C=C– bonds vibrations of the hydrated carboxyl group |
| 15 | 1630 | 1648 | Stretching vibrations of C=C bonds |
| 16 | 2910 | 2900 | Stretching C–H vibrations of CH2 groups |
| 17 | 3400 | 3400 | Stretching vibrations of the hydroxyl group |
| No. | C. vulgaris | A. platensis | Theoretical Interpretation |
|---|---|---|---|
| Wavenumber, cm−1 | |||
| 1 | - | 750–850 | Out-of-plane deformation vibrations of C–H bonds |
| 2 | 1044 | 1050 | Stretching vibration of C–C |
| 3 | 1193 | 1190 | Stretching vibration of carbonyl C–O groups |
| 4 | - | 1200 | Plane deformation vibrations of C–H |
| 5 | - | 1253 | Stretching vibration of O–H groups |
| 6 | 1400–1700 | 1400–1650 | Stretching vibrations of C=O, C=C bands, deformation vibrations of NH (δ(N–H)) |
| 7 | - | 2852 | Symmetrical stretching vibrations of –CH2– (νs(CH2)) |
| 8 | - | 2925 | Asymmetric stretching vibrations of –CH2– (νas(CH2)) |
| 9 | 2915,2940 | - | Stretching vibrations of –CH– (ν(CH)) |
| 10 | 3400 | - | Stretching vibrations of the hydroxyl group |
| 11 | - | 3735 | Stretching vibrations of N–H (ν(NH)) |
Publisher’s Note: MDPI stays neutral with regard to jurisdictional claims in published maps and institutional affiliations. |
© 2022 by the authors. Licensee MDPI, Basel, Switzerland. This article is an open access article distributed under the terms and conditions of the Creative Commons Attribution (CC BY) license (https://creativecommons.org/licenses/by/4.0/).
Share and Cite
Sukhikh, S.; Prosekov, A.; Ivanova, S.; Maslennikov, P.; Andreeva, A.; Budenkova, E.; Kashirskikh, E.; Tcibulnikova, A.; Zemliakova, E.; Samusev, I.; et al. Identification of Metabolites with Antibacterial Activities by Analyzing the FTIR Spectra of Microalgae. Life 2022, 12, 1395. https://doi.org/10.3390/life12091395
Sukhikh S, Prosekov A, Ivanova S, Maslennikov P, Andreeva A, Budenkova E, Kashirskikh E, Tcibulnikova A, Zemliakova E, Samusev I, et al. Identification of Metabolites with Antibacterial Activities by Analyzing the FTIR Spectra of Microalgae. Life. 2022; 12(9):1395. https://doi.org/10.3390/life12091395
Chicago/Turabian StyleSukhikh, Stanislav, Alexander Prosekov, Svetlana Ivanova, Pavel Maslennikov, Anna Andreeva, Ekaterina Budenkova, Egor Kashirskikh, Anna Tcibulnikova, Evgeniia Zemliakova, Ilia Samusev, and et al. 2022. "Identification of Metabolites with Antibacterial Activities by Analyzing the FTIR Spectra of Microalgae" Life 12, no. 9: 1395. https://doi.org/10.3390/life12091395
APA StyleSukhikh, S., Prosekov, A., Ivanova, S., Maslennikov, P., Andreeva, A., Budenkova, E., Kashirskikh, E., Tcibulnikova, A., Zemliakova, E., Samusev, I., & Babich, O. (2022). Identification of Metabolites with Antibacterial Activities by Analyzing the FTIR Spectra of Microalgae. Life, 12(9), 1395. https://doi.org/10.3390/life12091395

